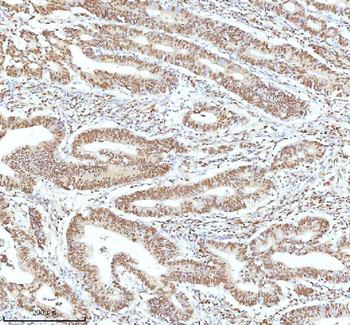
Ku70/XRCC6 Antibody
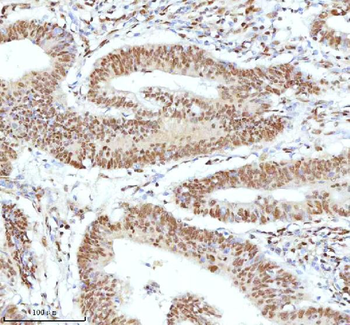
Ku70/XRCC6 Antibody

You have no items in your shopping cart.
- Collagen Type I Antibody [orb345343]
DOT, ELISA, FLISA, IHC, IP, WB
Bovine, Human, Mouse, Porcine, Rat
Rabbit
Polyclonal
Unconjugated
100 μg - Collagen Type I Antibody [orb345344]
DOT, ELISA, FLISA, IHC, IP, WB
Bovine, Human, Mouse, Porcine, Rat
Rabbit
Polyclonal
Unconjugated
500 μg - GFAP antibody [orb10706]Featured

ELISA, ICC, IF, IHC-P, WB
Human, Mouse, Rat
Rabbit
Polyclonal
Unconjugated
100 μg - HMGB1 antibody [orb195321]Featured

ELISA, ICC, IF, IHC-P, WB
Bovine, Human, Mouse, Rat
Rabbit
Polyclonal
Unconjugated
100 μg - CD8 antibody [orb323288]Featured

ELISA, ICC, IF, IHC-P, WB
Human, Mouse, Rat
Rabbit
Polyclonal
Unconjugated
100 μg - HnRNP H/HNRNPH1 Antibody [orb389415]
FC, ICC, IF, IHC, WB
Human, Mouse, Rat
Rabbit
Polyclonal
Unconjugated
100 μg